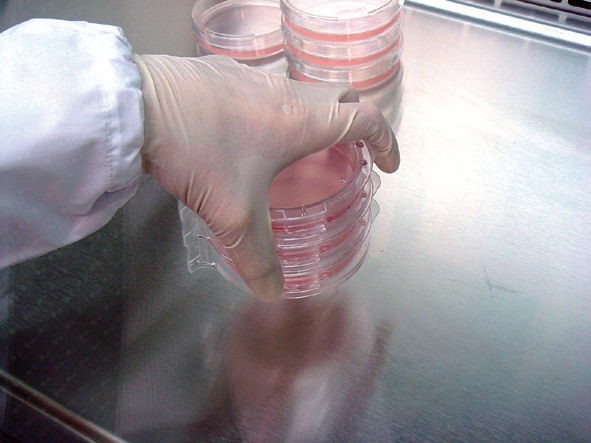
SHellDisH系列产品
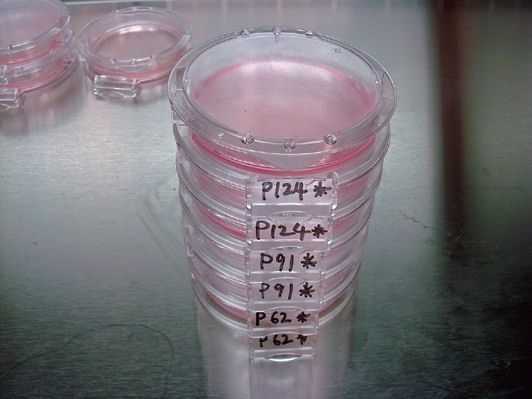
SHellDisH系列产品

SHellDisH系列产品
- 产品特性
- 相关资料
- Q&A
- 参考文献
SHellDisH 9020-C贝壳型培养皿(10个)
使用方便的高性能培养皿。培养面经过亲水处理,细胞附着性优良,可稳定培养细胞。

◆主要参数
|
产品编号 |
WEB26001 |
|
型号 |
9020-C贝壳型培养皿(10个) |
|
个数 |
10个/包 |
※经内毒素检测确认内毒素水平为0.5mL/EU。
※已取得国际专利
◆材质
 灭菌(电子束)
灭菌(电子束)
◆特点
只需用一根手指旋转盖子就能打开或锁上培养皿。
锁上后可防止移动时培养皿底脱落。
传统产品堆叠移动时,会拿不起下方的培养皿,或者出现脱落的情况。
SHellDisH贝壳型培养皿具有上锁功能,无需担心盖子和培养皿底分离。
实验过程中可安全移动或从恒温箱取放。
查看盖子边缘和标签部分是否重合可确认上锁状态。
上锁时不会产生振动导致细胞剥离。
上锁位置固定,即使在盖面上做了记号也不会找不到上锁的位置。
培养皿边上有专门写样本名称的空位,无需担心拿错培养皿。
为了方便区分和防止拿错,培养皿边上设有专门写标签的地方。堆叠起来也可清晰看到标签部分,方便管理。同时也便于孵育时进行观察。
只要拿着标签部分,就能在不影响样本温度的情况下进行实验操作。

只要将盖子突出的边缘插入标签部分内,即可使盖子保持打开状态。
双手在清洁台上工作时能有效活用空间,避免污染,盖子不会另外占用空间。

为了避免手指接触到培养皿和边缘而造成污染,培养皿的形状经过特别设计。
单手开盖时,手指不会接触到培养皿和边缘。独特的单手操作设计,缩短开盖时间,尽量减少掉落培养皿的细菌。

◆同系列产品
|
产品编号 |
产品名称 |
型号 |
包装 |
|
WEB26000 |
SHellDisH贝壳型培养皿 |
9020-C(一箱) |
200个/箱(10个/包×20) |
◆产品列表
|
产品编号 |
产品名称 |
包装 |
|
WEB26001 |
SHellDisH 9020-C贝壳型培养皿 |
10个/包 |
|
WEB26000S |
5个/包 |
|
|
WEB26001S |
1个 |
SHellDisH® I型骨胶原涂层培养皿

◆特点
● 本品由三博特与Nippi共同研发。
● 涂层材料为小牛真皮源I型骨胶原。
● 品质管理严格,产品干净,涂层均一。
● 通过细胞培养试验,可放心使用。
● 产品可在室温下稳定存放。
◆用途
● 促进细胞附着和伸展
● 细胞附着试验
● 细胞迅速增大
● 无血清或者低血清培养
● 改善初代培养细胞的活性及其生存率
◆注意事项
● 保管时请勿放在30℃以上或太阳直射的环境里,否则产品容易变质。
● 产品仅限研究使用,请勿用于治疗等其他用途。
◆产品列表
|
产品编号 |
产品名称 |
包装 |
|
WEB26003 |
ShellDish Cell Culture Dish |
1个/包 |
5个SHellDisH® 贝壳型培养皿专用铁架

◆特点
● 把SHellDisH 的标签部固定在架上,可一次固定5个SHellDisH,方便移动。
● 适合在研究室里使用,移动培养皿。
◆产品列表
|
产品编号 |
产品名称 |
包装 |
|
WEB26002 |
5个SHellDisH® 贝壳型培养皿专用铁架 |
1个 |
